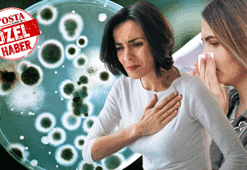
Sessiz katil! Milyonlarca insanı öldürüyor, saniyeler hayati önem taşıyor

Sepsis
Sepsis Haberleri
Son dakika sepsis haberleri ile ilgili Posta.com.tr'ye eklenen tüm haberler bu sayfada yer almaktadır. Geçmişte yaşanan sepsis gelişmeleri, bugün yaşanan en flaş gelişmeler ve çok daha fazlası sürekli güncel olan sepsis haber sayfamızda...

Basit bir enfeksiyon deyip geçmeyin! İlerlediğinde septik şoka sokuyor, hamilelerde ve bebeklerde dahi görülüyor!
9.02.2024
Basit bir enfeksiyon ile bile başlangıç gösterebilen o hastalık ilerlediğinde yaşam kalitesini tamamen düşürüp ölüm oranını yüzde 40 artırıyor! Uzmanı açıkladı: Hamile ve bebeklerde de görülüyor. İşte o kabus hastalık ve neler yapılması gerektiği...

Çocuklarda gastrit ve ülser hakkında merak edilenler
11.01.2024
Çocuk Gastroenterolojisi Uzmanı Doktor Meltem Gülşan, çocuklarda görülen gastrit ve ülserler hakkında bilgi verdi.

Grip teşhisi kondu, 24 saat sonra felaketi yaşadı: Kolları ve bacakları kesildi, sessiz katil canından ediyordu
16.11.2023
ABD'de yaşayan 42 yaşındaki Kristin Fox, adeta felaketi yaşadı. Boğaz ağrısı ile gittiği hastanede grip teşhisi konulduktan sonra evine gelen ve durumu kötüleşen genç kadın 24 saat geçmeden yeniden hastaneye kaldırıldı. İki çocuk annesi Fox'un vücudu o kadar ciddi komplikasyonlar geliştirdi ki, doktorlar hayatını kurtarmak için kollarını ve bacaklarını kesmek zorunda kaldı.

Sessiz katil: Sepsis
21.09.2023
Sepsis hastalığı toplumda oldukça yaygın görülüyor. Enfeksiyon Hastalıkları ve Mikrobiyoloji Uzmanı Prof. Dr. Fatma Nurhayat Saydam, sepsisin ne olduğu, kimlerde görüldüğü, neden olabileceği ve nasıl teşhis ve tedavi edildiğini sizler için anlatıyor.
Sessiz katil! Milyonlarca insanı öldürüyor, saniyeler hayati önem taşıyor
19.09.2023
Virüs ve bakterilerin artmasıyla ortaya çıkan sepsis, hayati bir risk taşıyor. Genellikle halk arasında kan zehirlenmesi olarak da bilinen sepsis, hemen müdahale edilmezse ölüme sebep oluyor. Enfeksiyon Hastalıkları ve Mikrobiyoloji Uzmanı Prof. Dr. Fatma Nurhayat Saydam, sepsis hastalığına dikkat çekerek önemli uyarılarda bulundu.

Trombosit düşüklüğü nedir? Trombosit (Plt) düşüklüğü neden olur, belirtileri nelerdir?
29.08.2023
Kan trombositleri, kırmızı kan hücreleri ve beyaz kan hücreleri ile kanda dolaşan, çekirdeği olmayan küçük hücrelerdir. Kan pıhtılaşmasında büyük rol oynarlar. Düşük, çok yüksek, normal değerleri vardır.

Yüzündeki yaralara 'sivilce' dediler... Genç kadının gizemli ölümü
5.04.2023
24 yaşındaki Bethannie Booth adlı kadın, grip ve soğuk algınlığı belirtileri gösteriyordu. Bunun yanında, yüzündeki yaralar için hastaneye başvuran kadına 'sivilce' geçirdiği söylendi. Hastalığı basit gibi görünse de birkaç gün sonra hayatını kaybetmesi şok etkisi yarattı.

Piyangoyu kazandığında ilk işi bunlar olmuştu… Genç milyonerin favori durağı Türkiye!
24.03.2023
Birleşik Krallık tarihinin en genç piyango kazananı olan milyoner Jane Park, aradan geçen 10 yılın ardından yaşadıklarını anlattı. Türkiye’ye sık sık geldiğini belirten Park, burada yaptırdığı estetiklerin hayatına etkisinden bahsetti.

Nejat İşler: Deprem beni depresyona soktu
4.03.2023
'Deli Yürek', 'Gülbeyaz', 'Aliye', 'Barda', 'Kış Uykusu' 'Kaybedenler Kulübü', 'Bodrum Masalı' ve 'Behzat Ç.' gibi projelerde kamera karşısına geçen Nejat İşler,önceki akşam arkadaşları ile Cihangir'de bir mekanda buluştu. Oyuncu, gazetecilerler de sohbet etti.

Depremzedeye ilk yardım nasıl olmalıdır?
15.02.2023
Deprem gibi afetlerde yaralıya müdahalede ilkyardımı iyi bilmek; herhangi bir enkazdan hayat kurtarabilmek için son derece önemlidir. En sık karşılaşılan yaralanmalar; iç ve dış kanamalar, kafa, göğüs, karın, göz yaralanmaları, ezik veya kırıklar ve yanmalardır. Enkaz altından yaralı çıkarırken dikkat edilmesi gereken pek çok husus var. Ortopedi ve Travmatoloji bölümünden Doç. Dr. Sinan Karaca, dikkat edilmesi gerekenleri açıkladı.

Grip diye hastaneye gitti, bacakları kesildi
1.02.2023
İngiltere’deki Willington Spor Kulübü’nün amatör futbolcusu Levi Dewey (21), 7 Kasım’da grip belirtileri ve nefes zorluğu şikayetiyle hastaneye başvurdu. Zatürre ve 'influenza b' teşhisi konulan Levi Dewey, durumu ağırlaşınca 31 gün boyunca uyutuldu. Ancak genç futbolcunun çilesi bununla bitmedi...

Strep A kabusu sürüyor: Ölmeden önce 3 kez hastaneye kaldırıldı
7.12.2022
İngiltere'de yayılan Strep A salgını korku salmaya devam ediyor. Küçük çocukların ölümüne neden olan salgındaki detaylar yürekleri yakıyor. Bir baba, 5 yaşındaki kızı Strep A nedeniyle hayatını kaybetmeden önce 3 kez hastaneye götürdüğünü açıkladı.

Hamile kadınların obezite olması ölüm riskini de artıyor
21.09.2022
İskoçya'da yapılan bir araştırmaya göre, artan obezite seviyeleri hamile kadınlar arasında ölüm oranlarına yol açmış olabilir. Anestezi dergisinde yayınlanan çalışmalarında bilim insanları, obez olan hamile kadınların yüzdesinin on yıl önce yüzde 20 iken 2021’de yüzde 26’ya yükseldiğine de dikkat çekiyor.

Çocuklarda yüksek ateşin sebebi kanda görülen enfeksiyon olabilir
23.07.2022
Çocuklarda ateşin en yaygın nedenin enfeksiyonlar olduğunu belirten Çocuk Sağlığı ve Hastalıkları Uzmanı Dr. Murat Aydın, “Soğuk algınlığı, grip, boğaz enfeksiyonları, sinüzit, bağırsak enfeksiyonları, kulak enfeksiyonları, krup, bronşiyolit ve idrar yolu enfeksiyonları ateşe neden olabilmektedir. Ateşe neden olabilecek en ciddi durumlar menenjit ve kanda enfeksiyon (sepsis) görülmesidir. Ayrıca sıcak çarpması, romatizmal hastalıklar, habis tümörler ve bazı ilaçlar da ateş yükselmesine neden olabilir” dedi.

Enfeksiyon hastalıkları zamanında tedavi edilmezse ölüme yol açabiliyor!
3.07.2022
Kana mikrop karışmasına tıp dilinde ‘sepsis’ adı veriliyor. Pek çok değişik tür mikrop çeşitli yollarla kana karışabiliyor ve hastalığa neden oluyor. Ancak enfeksiyon hastalıkları en acil tedavi gerektiren hastalıklarından biri. Zamanında ve etkin tedavi yapılamazsa organlarda hasar yaparak ölümle sonuçlanıyor. İşte kana mikrop karışması sonucunda ölüme kadar götürebilen enfeksiyon hastalıkları hakkında bilmeniz gerekenler...

Çocuklarda karaciğer büyümesi (Hepatomegali) neden olur?
20.05.2022
Bebeklerde ve çocuklarda bazı sorunlardan dolayı gelişen karaciğer büyümesi, bilimsel adıyla hepatomegali olarak bilinir. Doğumdan sonra her yaşta görülebilen karaciğer büyümesi, bazı bulgularla veya doktor muayenesi ile ortaya çıkabilir. Peki, çocuklarda karaciğer büyümesi neden olur? Bebeklerde karaciğer büyümesi nedenleri nelerdir? Karaciğer büyümesi nasıl geçer? İşte, çocuklarda ve bebeklerde karaciğer büyümesi nedenleri ve tedavi yöntemleri...

Popüler annelerden teknolojik tüyolar
30.04.2022
Bu yıl 8 Mayıs’ta kutlanacak Anneler Günü öncesi Türkiye’nin en popüler anneleriyle bir araya gelerek onlara hızla değişen dijital dünyayı ve bu özel günde nasıl bir teknolojik hediyenin kendilerini mutlu edebileceğini sorduk. Evet teknolojiden kopmamak hayati önem taşıyor ancak en güzel hediye elbette ailece bir arada olmak. Tabii ki sadece bir gün değil, bu paha biçilmez değeri onlara her gün hissettirmeliyiz.

Arkadaşının bıraktığı yemeği yedi, bacaklarından oldu
21.02.2022
Bir öğrenci, oda arkadaşının yarım bırakıp buzdolabına kaldırdığı tavuklu noodle'ı yedikten sonra bacaklarında sepsis meydana geldi ve bacakları ampüte edildi.

Covid-19'a bağlı olarak oluşan enfeksiyonlar çoklu organ yetmezliğine yol açabilir!
25.01.2022
Bakteriyel, viral ya da fungal enfeksiyonların iltihaplanmayı tetiklemesi sonucu ortaya çıkan savunma sistemi yanıtı, vücuttaki organların hasar görmesine yol açıyor. Sepsis olarak adlandırılan tabloda vücudun fizyolojik işlevlerinin bozulduğunu belirten uzmanlar, tanıyı alan kişilerin doğru ve yeterli tedavi edilmemeleri durumunda tekli veya çoklu organ yetmezliğinin oluşabileceğine dikkat çekiyor. Uzmanlar, çoklu organ yetmezliğinin birden çok organ ve sistemin etkilendiği bir durum olduğunu, tedavisiz kalması durumunda hastaları ölüme götürdüğünü vurguluyor.

Biyonik öğretmen: Protezler sayesinde mesleğine döndü
21.11.2021
İngiltere’de iki yıl önce geçirdiği ani hastalık sonucu dört uzvunu birden kaybeden öğretmen, biyonik protez teknolojisi sayesinde mesleğine döndü.

İstanbul’daki araştırmada ortaya çıktı! Şoke eden sonuç: 'Şalterleri' kapatıyor
8.11.2021
İstanbul’da yapılan bir araştırmada koronavirüsün etkilerinden birisi daha ortaya çıktı. Dünyanın en büyük kalp kongresi olan Amerikan Kalp Derneği'nin kongresinden ödül alan çalışmaya göre; koronavirüs hastalarında kısa bir süre içinde vücudu kanser ve kalp hastalıklarından koruyan protein düzeylerini çok düştüğü belirlendi. Koronavirüs kanser ya da kalp hastalıklarına neden olur mu? İşte detaylar…

Filiz Akın: Güzel kadın fakir gelip fakir gitmez; zenginle evlenir, havuzlu eve transfer olur
8.10.2021
Zarafet ve güzellik onun neredeyse diğer adı. Filiz Akın deyince, insana bir toparlanma, kendine çeki düzen verme hissi gelir. Yeşilçam’ın dört yapraklı yoncasından biri. Gerçek bir sinema emekçisi. Bircan Usallı SiLan ile ‘Hayatın Provası Yok’ adıyla bir nehir söyleşi kitabı çıkardılar ama bu aslında Filiz Akın’ın dördüncü kitabı. Biraz ‘Hayatın Provası Yok’ üzerine, biraz da başka şeyler üzerine konuştuk. Oya Çınar / oya.cinar@posta.com.tr

Parmağına batan diken nedeniyle ölümden döndü
3.09.2021
İngiltere'de yaşayan Jackie Jakson, parmağını sıyıran böğürtlen dikeni nedeniyle ölümden döndü. Elinde oluşan mantar enfeksiyonu kanına karıştığı için kan zehirlenmesi yani sepsis yaşayan talihsiz kadın tam 2 yıl boyunca hastanelerden çıkamadı. Dünya Sağlık Örgütü, 'Kanserden daha öldürücü' olarak tanımladı.

İhmal edilen sistit böbrekleri tehdit ediyor
27.02.2023
Sistit tedavi edilmediğinde böbreklere yayılarak böbrek iltihabına neden olabilir.
Üroloji Uzmanı Prof. Dr. Süleyman Ataus anlatıyor...

Ölümcül uygulama! Çamaşır ipiyle bel tedavisi yaptılar
26.06.2021
Doktor kontrolünde yapılması gereken ‘Geleneksel ve Tamamlayıcı Tıp Uygulamaları’ merdiven altına inince işkenceye dönüyor. Tedavi umuduyla buralara başvurup ölümle burun buruna gelenlerin son örneği Elazığ’da görüldü. Hastanın belinden iki adet delik açılmış ve deri altından çamaşır ipi geçirilmiş.